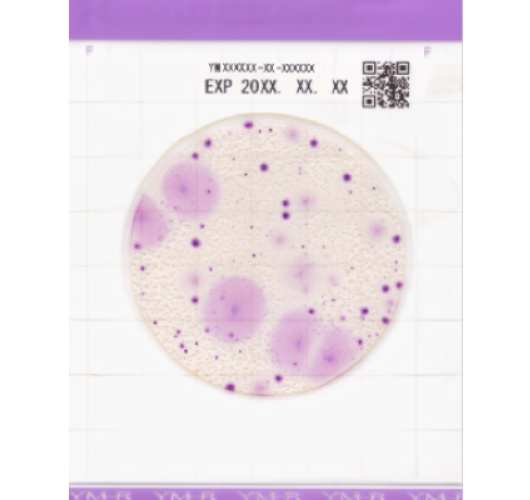

Плесень и дрожжи - Easy Plate YMR
Easy Plate YMR — это удобная пластина со средой для роста дрожжей и плесени.
Изменение цвета становится видимым в течение 48±2 часов, что позволяет легко идентифицировать и подсчитать колонии. Индикатор окислительно-восстановительного потенциала образует колонии фиолетового цвета, что облегчает идентификацию и подсчет колоний даже в присутствии остатков пищи. Колонии плесени распространяются на обширной территории и образуют колонии пурпурного цвета с разбросанными краями. Колонии дрожжей образуют небольшие круги с четкими краями.
Не требующая подготовки или стерилизации.
Время инкубации: 48 ± 2 часа
Температура инкубации: 25±1℃
Температура хранения: 2 - 8℃
Срок годности: 18 месяцев
Упаковка: 100 тестов (25 тестов х 4 пакета)